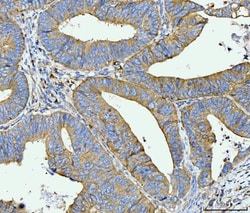
Invitrogen ACSL4 Monoclonal Antibody (4I7) 100 &mu;g; Unconjugated:Antibodies,

Learn More
Invitrogen™ ACSL4 Monoclonal Antibody (4I7)


Mouse Monoclonal Antibody
Brand: Invitrogen™ MA549273
Description
Adding 0.2 mL of distilled water will yield a concentration of 500 μg/mL. Positive Control - WB: human HepG2 whole cell, human PC-3 whole cell, human Hela whole cell, human Caco-2 whole cell. IHC: human bladder epithelial carcinoma tissue, human lung cancer tissue, human metaplasia of squamous cells of the renal pelvis tissue, human ovarian cancer tissue, human rectal moderately differentiated adenocarcinoma tissue. ICC/IF: SiHa cell. Flow: HepG2 cell. Store at -20°C for one year from date of receipt. After reconstitution, at 4°C for one month. It can also be aliquotted and stored frozen at -20°C for six months. Avoid repeated freeze-thaw cycles.
The protein encoded by this gene is an isozyme of the long-chain fatty-acid-coenzyme A ligase family. Although differing in substrate specificity, subcellular localization, and tissue distribution, all isozymes of this family convert free long-chain fatty acids into fatty acyl-CoA esters, and thereby play a key role in lipid biosynthesis and fatty acid degradation. This isozyme preferentially utilizes arachidonate as substrate. The absence of this enzyme may contribute to the mental retardation or Alport syndrome. Alternative splicing of this gene generates 2 transcript variants.
Specifications
| ACSL4 | |
| Monoclonal | |
| 500 μg/mL | |
| PBS with 4mg trehalose and no preservative | |
| O60488 | |
| Acsl4 | |
| A synthetic peptide corresponding to a sequence of human FACL4/ACSL4 (EPWTPETGLVTDAFKLKRKELR). | |
| 100 μg | |
| Primary | |
| Human | |
| Antibody | |
| IgG1 |
| Flow Cytometry, Immunohistochemistry (Paraffin), Western Blot, Immunocytochemistry | |
| 4I7 | |
| Unconjugated | |
| Acsl4 | |
| 9430020A05Rik; Acs4; ACSL4; acyl-CoA synthetase 4; acyl-CoA synthetase long-chain family member 4; Arachidonate--CoA ligase; AU018108; Facl4; fatty acid Coenzyme A ligase, long chain 4; fatty acid-Coenzyme A ligase long chain 4; fatty acid-Coenzyme A ligase, long chain 4; fatty-acid-Coenzyme A ligase, long-chain 4; L MRX63; LACS 4; Lacs4; lignoceroyl-CoA synthase; long-chain acyl-CoA synthetase 4; long-chain fatty-acid-Coenzyme A ligase 4; long-chain-fatty-acid--CoA ligase 4; mACS4; MRX63; MRX68 | |
| Mouse | |
| Antigen affinity chromatography | |
| RUO | |
| 2182 | |
| -20°C | |
| Lyophilized |
Your input is important to us. Please complete this form to provide feedback related to the content on this product.